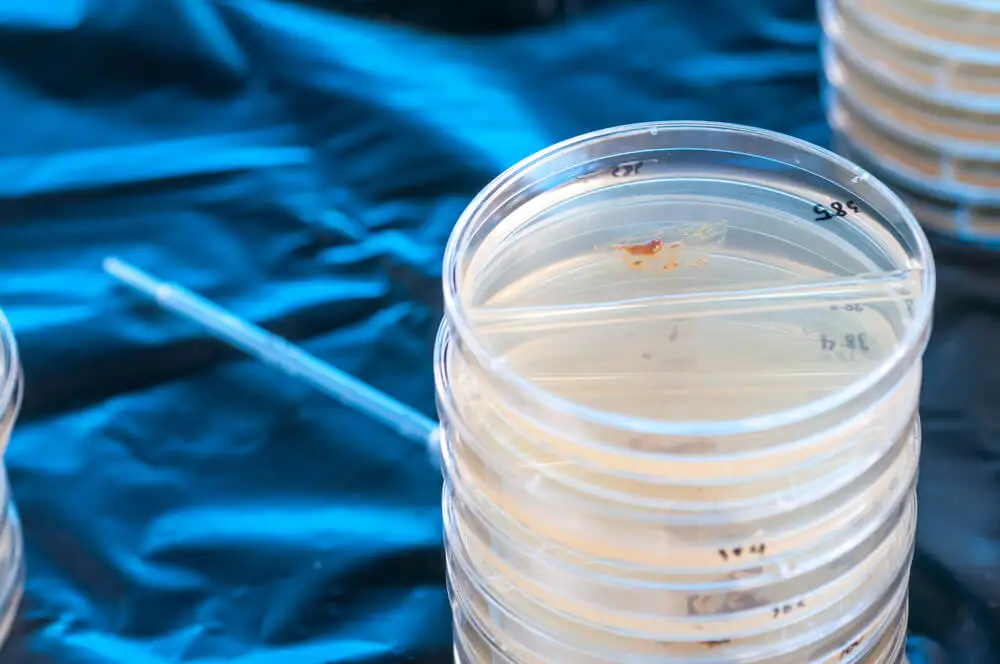

Heces alquitranosas: ¿qué significan?


Revisado y aprobado por el biotecnólogo Alejandro Duarte
Las heces alquitranosas hacen referencia a aquellas muestras de materia fecal que son de color rojo oscuro o negro. A menudo también se conocen como heces con sangre o melenas y suelen ser producto de una hemorragia o cualquier tipo de lesión en el tracto gastrointestinal.
No todos los casos de heces alquitranosas indican un problema grave, a pesar que su aspecto y olor fétido resultan alarmantes. De hecho, en ocasiones las heces se oscurecen por tomar alimentos oscuros, suplementos de hierro o medicamentos con Pepto-Bismol.
La atención y análisis de esta materia fecal puede ser determinante para el diagnóstico de algunas enfermedades graves. Por este motivo, es importante conocer qué significan, con qué patologías están relacionadas y cómo debe ser su tratamiento.
¿Qué significan las heces alquitranosas? ¿Cuáles son sus causas?
Para saber qué significan las heces alquitranosas hay que aprender a diferenciar los tipos de sangrado en las heces que se pueden producir. En muchos casos la sangre se oculta en las heces y no es posible detectarla a simple vista. Por eso, para determinarla puede ser necesaria una prueba conocida como test de guayaco.
Tipos de sangrado en las heces
- Heces alquitranosas: también se llaman melenas y son heces de color negro y olor fétido cuya causa principal suelen ser las hemorragias gastrointestinales altas.
- Hematoquecia: es una combinación de sangre clara y oscura en las deposiciones.
- Rectorragia: aparecen con un color claro y pueden darse por hemorragias gastrointestinales bajas o hemorroides.
Causas de las heces alquitranosas
La aparición de heces alquitranosas o negras suele indicar que la sangre proviene de la parte superior del tracto gastrointestinal, es decir, la región que abarca el esófago, estómago y la primera parte del intestino delgado.
La sangre suele adquirir un aspecto similar al del alquitrán luego de haber estado expuesta a los jugos digestivos. Algunos desencadenantes comunes son los siguientes:
- Traumatismos o infecciones.
- Úlceras sangrantes en el estómago.
- Vasos sanguíneos anormales (malformación vascular).
- Inflamación del revestimiento del estómago o gastritis.
- Venas grandes y protuberantes en el intestino o esófago (várices).
- Interrupción del riego sanguíneo a parte de los intestinos (isquemia intestinal).
- Desgarros en el esófago debido a vómitos muy fuertes (desgarro de Mallory-Weiss).
Cabe mencionar que existen otros factores que pueden teñir las heces de negro. Por ejemplo, los suplementos de hierro y medicamentos a base de bismuto pueden ocasionarlo. Además, a veces son producto de la ingestión de regaliz negro o arándanos. En estos casos el médico debe examinar las heces con un químico para descartar la sangre.
Lee también: El papel de las heces en el diagnostico clínico
Diagnóstico
La detección de sangre en las heces es un motivo de consulta médica urgente. Dado que puede indicar una enfermedad grave, es primordial recibir un diagnóstico preciso y oportuno. El médico iniciará con un examen físico y una serie de preguntas para completar la historia clínica.
A continuación, para determinar si existe alguna obstrucción o anormalidad que pueda estar causando una hemorragia gastrointestinal, puede sugerir otras pruebas de diagnóstico complementarias. Las que se emplean a menudo so las siguientes:
- Coprocultivo.
- Colonoscopias.
- Resonancias magnéticas (RM).
- Estudios con ingestión de bario.
- Esofagogastroduodenoscopia o EGD.
- Conteo sanguíneo completo (hemograma).
- Fórmula leucocitaria y estudios de coagulación.
- Radiografías y tomografías computarizadas (TC).
- Pruebas para comprobar infección por Helicobacter pylori.
Lee también: El color y la forma de las heces hablan sobre tu salud
Tratamiento para las heces alquitranosas

El tratamiento contra las heces alquitranosas varía en función de la patología o lesión que las ocasiona. De acuerdo con información de la Sociedad Estadounidense del Cáncer (ACS, por sus siglas en inglés), los pacientes que sufren hemorroides pueden disminuir la hemorragia al utilizar laxantes recomendados por el médico.
Otras medidas utilizadas en este tipo de casos son los baños de asiento y pomadas a base de corticoides. Cuando el sangrado se debe a úlceras sangrantes, el médico puede recetar medicamentos antiácidos. Si su origen son afecciones intestinales inflamatorias o infecciones, el tratamiento puede incluir antibióticos e inmunosupresores.
Dado que en algunos casos la hemorragia no se detiene de forma espontánea, a veces es necesaria una intervención quirúrgica. Por lo general se toma esta medida por obstrucciones venosas o anomalías en el sistema. También se puede sugerir una transfusión de sangre en caso que el sangrado sea abundante.
La presencia de sangre en las heces a veces se origina por pólipos en el colon. Estos, casi siempre, indican afecciones precancerosas o cáncer en los pacientes. De confirmarse este tipo de diagnóstico el profesional sugiere una cirugía para extirpar los pólipos, o bien, quimioterapia y radioterapia, si fuese necesario.
Todas las fuentes citadas fueron revisadas a profundidad por nuestro equipo, para asegurar su calidad, confiabilidad, vigencia y validez. La bibliografía de este artículo fue considerada confiable y de precisión académica o científica.
- McQuaid KR. Approach to the patient with gastrointestinal disease. In: Goldman L, Schafer AI, eds. Goldman-Cecil Medicine. 25th ed. Philadelphia, PA: Elsevier Saunders; 2016:chap 132.
- Meguerdichian DA, Goralnick E. Gastrointestinal bleeding. In: Walls RM, Hockberger RS, Gausche-Hill M, eds. Rosen’s Emergency Medicine: Concepts and Clinical Practice. 9th ed. Philadelphia, PA: Elsevier; 2018:chap 27.
- Kumar, R., & Mills, A. M. (2011). Gastrointestinal Bleeding. Emergency Medicine Clinics of North America. https://doi.org/10.1016/j.emc.2011.01.003
- Rockey, D. C. (2005). Occult gastrointestinal bleeding. Gastroenterology Clinics of North America. https://doi.org/10.1016/j.gtc.2005.08.010
Este texto se ofrece únicamente con propósitos informativos y no reemplaza la consulta con un profesional. Ante dudas, consulta a tu especialista.







